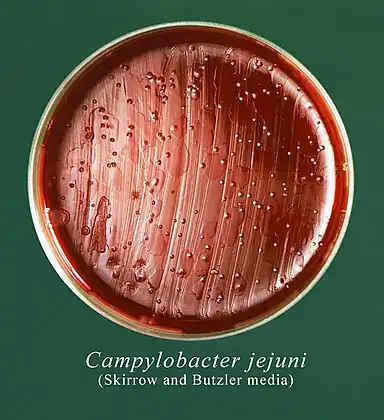
This Petri dish culture plate contained Skirrow and Butzler growth medium, which had been inoculated with a culture of Campylobacter jejuni, formerly known as Campylobacter fetus subsp. jejuni, and had produced numerous, small round bacterial colonies. Campylobacteriosis is an infectious disease caused by bacteria of the genus Campylobacter. Most people who become ill with campylobacteriosis have diarrhea, cramping, abdominal pain, and fever within 2 to 5-days after exposure to the organism.

Campylobacteriosis
| Campylobacteriosis | |
|---|---|
| Other names: Campylobacter food poisoning – campylobacter enteritis[1] | |
 .png.webp) | |
| |
| Specialty | Infectious disease |
| Symptoms | Diarrhea, abdominal pain, fever |
| Complications | toxic megacolon, dehydration, sepsis, Guillain–Barré syndrome |
| Causes | Campylobacter jejuni |
| Diagnostic method | Gram stain of stool sample |
| Treatment | Supportive care, Antibiotics (select cases) |
| Prognosis | Usually self-limited |
| Deaths | Infrequent |
Campylobacteriosis is an infection by the Campylobacter bacterium, most commonly C. jejuni.[3][4]Campylobacteriosis is usually self-limiting and antimicrobial treatment is often not required, except in severe cases or immunocompromised individuals.[5] The most known source for Campylobacter is poultry, but due to their diverse natural reservoir, Campylobacter spp. can also be transmitted via water.[6]Other known sources of Campylobacter infections include food products, such as unpasteurised milk and contaminated fresh produce.[7]
It is among the most common bacterial infections of humans, often a foodborne illness. It produces an inflammatory, sometimes bloody, diarrhea or dysentery syndrome, mostly including cramps, fever and pain.[8]
Symptoms and signs
The prodromal symptoms are fever, headache, and myalgia, which can be severe, lasting as long as 24 hours. After 1–5 days, typically, these are followed by diarrhea or dysentery, cramps, abdominal pain, and fever, in most people, the illness lasts for 2–10 days. It is classified as invasive/inflammatory diarrhea, also described as bloody diarrhea or dysentery.There are other diseases showing similar symptoms, for instance, abdominal pain and tenderness may be very localized, mimicking appendicitis. Furthermore, Helicobacter pylori is closely related to Campylobacter and causes peptic ulcer disease.[9][10][1][11][12]
Complications

Complications include toxic megacolon, dehydration and sepsis. Such complications generally occur in young children and immunocompromised people.[13]
A chronic course of the disease is possible; this disease process is likely to develop without a distinct acute phase. Chronic campylobacteriosis features a long period of sub-febrile temperature and asthenia, also arthritis, may develop if infection is untreated.[14]
Occasional deaths occur in young, previously healthy individuals because of blood volume depletion, and in persons who are elderly or immunocompromised. Some individuals develop Guillain–Barré syndrome, in which the nerves that join the spinal cord and brain to the rest of the body are damaged, sometimes permanently. This occurs only with infection of C. jejuni and C. upsaliensis.[15][16][17]
Cause
Campylobacteriosis is caused by Campylobacter bacteria (curved or spiral, motile, non–spore-forming, Gram-negative rods). The disease is usually caused by C. jejuni, a spiral and comma-shaped bacterium normally found in cattle, swine, and birds, where it is nonpathogenic, but the illness can also be caused by C. coli (swine, and birds[18]), C. upsaliensis (cats and dogs[19]) and C. lari (seabirds[18]).One effect of campylobacteriosis is tissue injury in the gut, the sites of tissue injury include the jejunum, and the colon, C jejuni appears to achieve this by invading and destroying epithelial cells.[20][21][22]
C. jejuni can also cause a latent autoimmune effect on the nerves of the legs, which is usually seen several weeks after a surgical procedure of the abdomen. The effect is known as an acute idiopathic demyelinating polyneuropathy, in which one sees symptoms of ascending paralysis, dysaesthesias usually below the waist, and, in the later stages, respiratory problems[17].Some strains of C jejuni produce a cholera-like enterotoxin, which is important in watery diarrhea observed in infections. The organism produces diffuse, bloody, edematous, and exudative enteritis.[23][22]
 Campylobacter species arrows stained by 1% carbol fuchsin
Campylobacter species arrows stained by 1% carbol fuchsin This Petri dish culture plate contained Skirrow and Butzler growth medium, which had been inoculated with a culture of Campylobacter jejuni, formerly known as Campylobacter fetus subsp. jejuni, and had produced numerous, small round bacterial colonies. Campylobacteriosis is an infectious disease caused by bacteria of the genus Campylobacter. Most people who become ill with campylobacteriosis have diarrhea, cramping, abdominal pain, and fever within 2 to 5-days after exposure to the organism.
This Petri dish culture plate contained Skirrow and Butzler growth medium, which had been inoculated with a culture of Campylobacter jejuni, formerly known as Campylobacter fetus subsp. jejuni, and had produced numerous, small round bacterial colonies. Campylobacteriosis is an infectious disease caused by bacteria of the genus Campylobacter. Most people who become ill with campylobacteriosis have diarrhea, cramping, abdominal pain, and fever within 2 to 5-days after exposure to the organism. Campylobacter bacteria are the number-one cause of food-related gastrointestinal illness in the United States. This scanning electron microscope image shows the characteristic spiral, or corkscrew, shape of C. jejuni cells and related structures.
Campylobacter bacteria are the number-one cause of food-related gastrointestinal illness in the United States. This scanning electron microscope image shows the characteristic spiral, or corkscrew, shape of C. jejuni cells and related structures.
Risk factors
In individuals with HIV, infections may be more frequent, may cause prolonged bouts of diarrhea, and may be more commonly associated with bacteremia and antibiotic resistance. The severity and persistence of infection in patients with AIDS and hypogammaglobulinemia indicates that both cell-mediated and humoral immunity are important in preventing and terminating infection.[24][25][26][27]
Transmission

The common routes of transmission for the disease-causing bacteria are fecal-oral, person-to-person sexual contact, ingestion of contaminated food , generally unpasteurized (raw) milk and undercooked or poorly handled poultry, and waterborne. Contact with contaminated poultry, livestock, or household pets, especially puppies, can also cause disease.[28][29][30]
Animals farmed for meat are the main source of campylobacteriosis. A study published in PLoS Genetics (26 September 2008) by researchers from Lancashire, England, and Chicago, Illinois, found that 97 percent of campylobacteriosis cases sampled in Lancashire were caused by bacteria typically found in chicken and livestock. In 57 percent of cases, the bacteria could be traced to chicken, and in 35 percent to cattle. Wild animal and environmental sources were accountable for just three percent of disease.[31][32]
The infectious dose is 1000–10,000 bacteria, although ten to five hundred bacteria can be enough to infect humans. Campylobacter species are sensitive to hydrochloric acid in the stomach, and acid reduction treatment can reduce the amount of inoculum needed to cause disease.Exposure to bacteria is often more common during travelling, and therefore campylobacteriosis is a common form of travelers' diarrhea.[33][34][22][35]
Diagnosis
Campylobacter organisms can be detected by performing a Gram stain of a stool sample with high specificity and a sensitivity, but are most often diagnosed by stool culture. Fecal leukocytes should be present and indicate the diarrhea to be inflammatory in nature. Methods currently being developed to detect the presence of campylobacter organisms include antigen testing via an ELISA or PCR.[36][37]
Prevention
.jpg.webp)
Among the current methods for prevention are the following:[38][39]
- Pasteurization of milk and chlorination of drinking water destroys the organisms.
- Infected health care workers should not provide direct patient care.
- Separate cutting boards should be used for foods of animal origin and other foods, after preparing raw food of animal origin, all cutting boards and countertops should be carefully cleaned with soap and hot water.
- Contact with pet saliva and feces should be avoided.
The World Health Organization recommends the following:[40][41]
- Food should be properly cooked and hot when served.
- Consume only pasteurized or boiled milk and milk products, never raw milk products.
- Make sure that ice is from safe water.
- If you are not sure of the safety of drinking water, boil it, or disinfect it with chemical disinfectant.
- Wash hands thoroughly and frequently with soap, especially after using the toilet and after contact with pets and farm animals.
- Wash fruits and vegetables thoroughly, especially if they are to be eaten raw. Peel fruits and vegetables whenever possible.
- Food handlers, professionals and at home, should observe hygienic rules during food preparation.
- Professional food handlers should immediately report to their employer any fever, diarrhea, vomiting or visible infected skin lesions.
Treatment

The infection is usually self-limiting, and in most cases, symptomatic treatment by liquid and electrolyte replacement is enough in human infections.[36]
Antibiotics
Antibiotic treatment only has a marginal effect on the duration of symptoms, and its use is not recommended except in high-risk patients with clinical complications.[42]
Erythromycin can be used in children, and tetracycline in adults. Some studies show, however, that erythromycin rapidly eliminates Campylobacter from the stool without affecting the duration of illness. Nevertheless, children with dysentery due to C. jejuni benefit from early treatment with erythromycin. Treatment with antibiotics, therefore, depends on the severity of symptoms. Quinolones are effective if the organism is sensitive, but high rates of quinolone use in livestock mean that quinolones are now largely ineffective.[43][44][45]
In animals
In the past, poultry infections were often treated by mass administration of enrofloxacin and sarafloxacin for single instances of infection. The FDA banned this practice, as it promoted the development of fluoroquinolone-resistant populations.[46] A major broad-spectrum fluoroquinolone used in humans is ciprofloxacin, currently growing resistance of the Campylobacter to fluoroquinolones and macrolides is of a major concern.[47]
Prognosis
Campylobacteriosis is usually self-limited without any mortality, assuming proper hydration is maintained,however, there are several possible complications.[21]
Epidemiology

Campylobacter is one of the most common causes of human bacterial gastroenteritis.[49] For instance, an estimated 2 million cases of Campylobacter enteritis occur annually in the U.S., accounting for 5–7% of cases of gastroenteritis. Furthermore, in the United Kingdom during 2000, Campylobacter jejuni was involved in 77.3% in all cases of laboratory confirmed foodborne illness.[50] About 20 of every 100,000 people are diagnosed with campylobacteriosis every year, and with many cases going unreported.[51]
Unfortunately, the true incidence of campylobacteriosis is unknown in most countries, especially developing countries. The reasons are among others underreporting, difficulties with diagnosis and differences in reporting systems in different countries.[52]
A large animal reservoir is present as well, with up to 100% of poultry, including chickens, turkeys, and waterfowl, having asymptomatic infections in their intestinal tracts. Infected chicken feces may contain up to 105-108 CFU/g, and due to the animals' close proximity, the bacteria are rapidly spread to other chickens. In January 2013, the UK's Food Standards Agency warned that high percentage of all raw chicken bought from UK shops was contaminated with campylobacter, affecting an estimated half a million people annually.[53][54][55]
Outbreak
In August–September 2016, 5,200 people fell ill with campylobacteriosis in Hastings, New Zealand after the local water supply in Havelock North tested positive for the pathogen Campylobacter jejuni.[56][57] Four deaths were suspected to be due to the outbreak.[58] It is suspected that after heavy rain fell on 5–6 August, water contamination from flooding caused the outbreak, although this is the subject of a government Inquiry.[59] It is the largest outbreak of waterborne disease ever to occur in New Zealand. All schools in Havelock North closed, with the Hastings District Council advising an urgent notice to boil water for at least one minute before consumption, this notice was lifted when the outbreak was officially under control.[60][61]
According to Centers for Disease Control and Prevention, a multistate outbreak of human Campylobacter infection has been reported since 11 September 2017. In all, 55 cases were reported from 12 states (Florida, Kansas, Maryland, Missouri, New Hampshire, New York, Ohio, Pennsylvania, Tennessee, Utah, Wisconsin and Wyoming). Epidemiological and laboratory evidence indicated that puppies sold through Petland stores were a likely source of this outbreak. Out of 55 cases reported, 50 were either employees of Petland or had recently purchased a puppy at Petland, or visited there before illness began. Five people out of 55 cases reported were exposed to puppies from various sources.[62]
Campylobacter can spread through contact with dog feces. It usually does not spread from one person to another. However, activities such as changing an infected person's diapers or sexual contact with an infected person can lead to infection. Regardless of where they are from, any puppies and dogs may carry Campylobacter germs.[62]
References
- 1 2 "Campylobacter infection: MedlinePlus Medical Encyclopedia". medlineplus.gov. Archived from the original on 27 July 2019. Retrieved 20 July 2019.
- ↑ Fu, Ying; Alenezi, Tahrir; Almansour, Ayidh; Wang, Hong; Jia, Zhenquan; Sun, Xiaolun (18 March 2021). "The Role of Immune Response and Microbiota on Campylobacteriosis". Campylobacter. IntechOpen.
- ↑ cdc.gov Archived 10 December 2017 at the Wayback Machine Centers for disease Control and Prevention
- ↑ Barlow, Gavin; Irving, William L.; Moss, Peter J. (2020). "20. Infectious disease". In Feather, Adam; Randall, David; Waterhouse, Mona (eds.). Kumar and Clark's Clinical Medicine (10th ed.). Elsevier. pp. 539–541. ISBN 978-0-7020-7870-5. Archived from the original on 6 May 2022. Retrieved 6 May 2022.
- ↑ Skarp CP, Hänninen ML, Rautelin HI (February 2016). "Campylobacteriosis: the role of poultry meat". Clinical Microbiology and Infection. 22 (2): 103–109. doi:10.1016/j.cmi.2015.11.019. PMID 26686808.
- ↑ Humphrey, Tom; O'Brien, Sarah; Madsen, Mogens (15 July 2007). "Campylobacters as zoonotic pathogens: A food production perspective". International Journal of Food Microbiology. 117 (3): 237–257. doi:10.1016/j.ijfoodmicro.2007.01.006. ISSN 0168-1605. Retrieved 3 May 2023.
- ↑ "Infectious disease Campylobacter clinical Foodborne illnesses | CDC". www.cdc.gov. Archived from the original on 18 June 2022. Retrieved 14 February 2016.
- ↑ Sarkar, S. R.; Hossain, M. A.; Paul, S. K.; Ray, N. C.; Sultana, S.; Rahman, M. M.; Islam, A. (January 2014). "Campylobacteriosis - an overview". Mymensingh Medical Journal: MMJ. 23 (1): 173–180. ISSN 1022-4742. PMID 24584395. Archived from the original on 16 March 2022. Retrieved 27 April 2023.
- ↑ Merrell, D. Scott; Stintzi, Alain (2012). "Research advances in the study of Campylobacter, Helicobacter, and Related Organisms". Frontiers in Cellular and Infection Microbiology. 2: 159. doi:10.3389/fcimb.2012.00159. PMC 3525878. PMID 23267439.
- ↑ "Symptoms | Campylobacter | CDC". www.cdc.gov. 23 December 2019. Archived from the original on 6 March 2023. Retrieved 27 April 2023.
- ↑ Fischer, Greg H.; Paterek, Elizabeth (2023). "Campylobacter". StatPearls. StatPearls Publishing. PMID 30725718. Archived from the original on 20 July 2022. Retrieved 27 April 2023.
- ↑ Dooley, C. P. (1991). "Helicobacter pylori: review of research findings". Alimentary Pharmacology & Therapeutics. 5 Suppl 1: 129–143. doi:10.1111/j.1365-2036.1991.tb00756.x. ISSN 0269-2813. Archived from the original on 30 June 2023. Retrieved 9 May 2023.
- ↑ Saxena, Shailendra K. (21 November 2019). Water-Associated Infectious Diseases. Springer Nature. p. 33. ISBN 978-981-13-9197-2. Archived from the original on 30 June 2023. Retrieved 12 May 2023.
- ↑ Nachamkin, Irving (1 April 2002). "Chronic effects of Campylobacter infection". Microbes and Infection. 4 (4): 399–403. doi:10.1016/S1286-4579(02)01553-8. ISSN 1286-4579. Retrieved 13 May 2023.
- ↑ Medical microbiology, Murray, P.R. and others. 2002 Mosby St. Louis
- ↑ "Campylobacter Infections". HealthyChildren.org. American Academy of Pediatrics. Archived from the original on 27 November 2022. Retrieved 27 April 2023.
- 1 2 Poropatich, KO; Walker, CL; Black, RE (December 2010). "Quantifying the association between Campylobacter infection and Guillain-Barré syndrome: a systematic review". Journal of health, population, and nutrition. 28 (6): 545–52. doi:10.3329/jhpn.v28i6.6602. PMID 21261199. Archived from the original on 20 August 2022. Retrieved 13 May 2023.
- 1 2 Forsythe, Stephen J. (7 January 2020). The Microbiology of Safe Food. John Wiley & Sons. p. 147. ISBN 978-1-119-40501-6. Archived from the original on 30 June 2023. Retrieved 7 May 2023.
- ↑ Greene, Craig E.; Calpin, Janet; Guptill, Lynn (1 January 2008). "CHAPTER 113 - Bacterial Infections". Handbook of Small Animal Practice (Fifth Edition). W.B. Saunders. pp. 1104–1114. ISBN 978-1-4160-3949-5. Retrieved 7 May 2023.
- ↑ Kreling, Vanessa; Falcone, Franco H.; Kehrenberg, Corinna; Hensel, Andreas (December 2020). "Campylobacter sp.: Pathogenicity factors and prevention methods—new molecular targets for innovative antivirulence drugs?". Applied Microbiology and Biotechnology. 104 (24): 10409–10436. doi:10.1007/s00253-020-10974-5. PMC 7662028. PMID 33185702.
- 1 2 "Campylobacter Infections: Background, Pathophysiology, Epidemiology". Medscape. 23 March 2023. Archived from the original on 4 April 2023. Retrieved 3 May 2023.
- 1 2 3 Kirkpatrick, Beth D.; Tribble, David R. (January 2011). "Update on human Campylobacter jejuni infections". Current Opinion in Gastroenterology. 27 (1): 1–7. doi:10.1097/MOG.0b013e3283413763. ISSN 1531-7056. Archived from the original on 20 June 2022. Retrieved 4 May 2023.
- ↑ Kurjak, Asim; Chervenak, Frank A. (25 September 2006). Textbook of Perinatal Medicine. CRC Press. p. 1748. ISBN 978-1-4398-1469-7. Archived from the original on 29 April 2023. Retrieved 29 April 2023.
- ↑ "Campylobacteriosis | NIH". clinicalinfo.hiv.gov. Archived from the original on 24 November 2021. Retrieved 27 April 2023.
- ↑ Tee, W.; Mijch, A. (January 1998). "Campylobacter jejuni bacteremia in human immunodeficiency virus (HIV)-infected and non-HIV-infected patients: comparison of clinical features and review". Clinical Infectious Diseases: An Official Publication of the Infectious Diseases Society of America. 26 (1): 91–96. doi:10.1086/516263. ISSN 1058-4838. PMID 9455515. S2CID 37440443. Archived from the original on 15 June 2022. Retrieved 27 April 2023.
- ↑ Vaishnavi, Chetana (31 March 2013). Infections of the Gastrointestinal System. JP Medical Ltd. p. 271. ISBN 978-93-5090-352-0. Archived from the original on 30 June 2023. Retrieved 10 May 2023.
- ↑ Najjar, Iris; Paluca, Florina; Loukidis, Konstantinos; Tarr, Philip E. (18 February 2020). "Recurrent Campylobacter Enteritis in Patients with Hypogammaglobulinemia: Review of the Literature". Journal of Clinical Medicine. 9 (2): 553. doi:10.3390/jcm9020553. Archived from the original on 30 June 2023. Retrieved 10 May 2023.
- ↑ Saenz Y, Zarazaga M, Lantero M, Gastanares MJ, Baquero F, Torres C (2000). "Antibiotic resistance in Campylobacter strains isolated from animals, foods, and humans in Spain in 1997–1998". Antimicrob Agents Chemother. 44 (2): 267–71. doi:10.1128/AAC.44.2.267-271.2000. PMC 89669. PMID 10639348.
- ↑ Mughini-Gras, Lapo; Pijnacker, Roan; Coipan, Claudia; Mulder, Annemieke C.; Fernandes Veludo, Adriana; de Rijk, Sharona; van Hoek, Angela H.A.M.; Buij, Ralph; Muskens, Gerard; Koene, Miriam; Veldman, Kees; Duim, Birgitta; van der Graaf-van Bloois, Linda; van der Weijden, Coen; Kuiling, Sjoerd; Verbruggen, Anjo; van der Giessen, Joke; Opsteegh, Marieke; van der Voort, Menno; Castelijn, Greetje A.A.; Schets, Franciska M.; Blaak, Hetty; Wagenaar, Jaap A.; Zomer, Aldert L.; Franz, Eelco (February 2021). "Sources and transmission routes of campylobacteriosis: A combined analysis of genome and exposure data". Journal of Infection. 82 (2): 216–226. doi:10.1016/j.jinf.2020.09.039. PMID 33275955. S2CID 227297981. Archived from the original on 28 April 2023. Retrieved 28 April 2023.
- ↑ Silva, Joana; Leite, Daniela; Fernandes, Mariana; Mena, Cristina; Gibbs, Paul Anthony; Teixeira, Paula (2011). "Campylobacter spp. as a Foodborne Pathogen: A Review". Frontiers in Microbiology. 2. doi:10.3389/fmicb.2011.00200. Archived from the original on 2 April 2023. Retrieved 1 May 2023.
- ↑ Animals Farmed for Meat Are the Number 1 Source of Food Poisoning Bug Archived 4 October 2011 at the Wayback Machine Newswise, Retrieved on September 23, 2008.
- ↑ Wilson DJ, Gabriel E, Leatherbarrow AJH, Cheesbrough J, Gee S, Bolton E, Fox A, Fearnhead P, Hart CA, Diggle PJ (2008). "Tracing the source of campylobacteriosis". PLOS Genet. 4 (9): e1000203. doi:10.1371/journal.pgen.1000203. PMC 2538567. PMID 18818764.
- ↑ Igwaran, Aboi; Okoh, Anthony Ifeanyi (November 2019). "Human campylobacteriosis: A public health concern of global importance". Heliyon. 5 (11): e02814. Bibcode:2019Heliy...502814I. doi:10.1016/j.heliyon.2019.e02814. PMC 6861584. PMID 31763476.
- ↑ "Campylobacteriosis - Chapter 4 - 2020 Yellow Book | Travelers' Health | CDC". wwwnc.cdc.gov. Archived from the original on 6 February 2023. Retrieved 6 May 2023.
- ↑ Perez-Perez, Guillermo I.; Blaser, Martin J. (1996). "Campylobacter and Helicobacter". Medical Microbiology (4th ed.). University of Texas Medical Branch at Galveston. ISBN 978-0-9631172-1-2. Archived from the original on 23 March 2021. Retrieved 7 May 2023.
- 1 2 "Diagnosis and Treatment". The CDC. Archived from the original on 18 May 2021. Retrieved 23 July 2021.
- ↑ "Bacteria Culture Test: MedlinePlus Medical Test". medlineplus.gov. Archived from the original on 15 March 2023. Retrieved 27 April 2023.
- ↑ "Campylobacter". www.who.int. Archived from the original on 11 April 2020. Retrieved 1 May 2023.
- ↑ "Prevention | Campylobacter | CDC". www.cdc.gov. 20 December 2019. Archived from the original on 6 March 2023. Retrieved 27 April 2023.
- ↑ "Campylobacter". Health Topics A TO Z. Archived from the original on 18 January 2011. Retrieved 6 March 2011.
- ↑ "Campylobacter". USDA. Archived from the original on 22 April 2023. Retrieved 2 May 2023.
- ↑ Ternhag A, Asikainen T, Giesecke J, Ekdahl K (2007). "A meta-analysis on the effects of antibiotic treatment on duration of symptoms caused by infection with Campylobacter species". Clin Infect Dis. 44 (5): 696–700. doi:10.1086/509924. PMID 17278062.
- ↑ "Campylobacter Infections Medication: Antibiotics". emedicine.medscape.com. Archived from the original on 9 October 2022. Retrieved 8 May 2023.
- ↑ Goldman, Lee; Schafer, Andrew I. (21 April 2015). Goldman-Cecil Medicine E-Book. Elsevier Health Sciences. p. 101. ISBN 978-0-323-32285-0. Archived from the original on 1 May 2023. Retrieved 30 April 2023.
- ↑ Fàbrega A, Sánchez-Céspedes J, Soto S, Vila J (2008). "Quinolone resistance in the food chain". Int J Antimicrob Agents. 31 (4): 307–15. doi:10.1016/j.ijantimicag.2007.12.010. PMID 18308515.
- ↑ McDermott P, Bodeis S, English L, White D, Walker R, Zhao S, Simjee S, Wagner D (2002). "Ciprofloxacin resistance in Campylobacter jejuni evolves rapidly in chickens treated with fluoroquinolones". J Infect Dis. 185 (6): 837–40. doi:10.1086/339195. PMID 11920303.
- ↑ Qin, Xiaoxia; Wang, Xin; Shen, Zhangqi (January 2023). "The rise of antibiotic resistance in Campylobacter". Current Opinion in Gastroenterology. 39 (1): 9. doi:10.1097/MOG.0000000000000901. ISSN 0267-1379. Archived from the original on 13 December 2022. Retrieved 30 April 2023.
- ↑ Arsenault, Julie; Berke, Olaf; Michel, Pascal; Ravel, André; Gosselin, Pierre (22 November 2012). "Environmental and demographic risk factors for campylobacteriosis: do various geographical scales tell the same story?". BMC Infectious Diseases. 12: 318. doi:10.1186/1471-2334-12-318. ISSN 1471-2334. PMC 3570353. PMID 23173982.
- ↑ "Gastritis". The Lecturio Medical Concept Library. Archived from the original on 23 July 2021. Retrieved 22 July 2021.
- ↑ "Food Standards Agency". food.gov.uk. Archived from the original on 4 December 2003. Retrieved 5 April 2018.
- ↑ "Questions and Answers | Campylobacter | CDC". www.cdc.gov. 16 February 2023. Archived from the original on 7 December 2017. Retrieved 6 May 2023.
- ↑ Hansson, Ingrid (2018). "Knowledge gaps in control of Campylobacter for prevention of campylobacteriosis". Transbounding and Emerging Diseases. 65 (S1): 30–48. doi:10.1111/tbed.12870. PMID 29663680.
- ↑ "FSA warns that chicken bacteria could be next meat scandal". 5 April 2018. Archived from the original on 3 December 2017. Retrieved 5 April 2018 – via www.telegraph.co.uk.
- ↑ "A REFRESHED STRATEGY TO REDUCE CAMPYLOBACTERIOSIS FROM POULTRY" (PDF). Food Standards agency. Archived (PDF) from the original on 20 June 2022. Retrieved 10 May 2023.
- ↑ Facciolà, A; Riso, R; Avventuroso, E; Visalli, G; Delia, SA; Laganà, P (June 2017). "Campylobacter: from microbiology to prevention". Journal of preventive medicine and hygiene. 58 (2): E79–E92. PMID 28900347. Archived from the original on 28 March 2023. Retrieved 12 May 2023.
- ↑ "Something in the water – How the Havelock gastro outbreak began". The New Zealand Herald. 19 August 2016. Archived from the original on 7 February 2019. Retrieved 4 February 2019.
- ↑ "A cautionary tale of untreated groundwater, Campylobacter, and New Zealand's largest drinking water outbreak". Water Quality and Health Council. 21 October 2016. Archived from the original on 7 February 2019. Retrieved 4 February 2019.
- ↑ Mitchell, Charlie (13 March 2020). "Schools, hospital among providers of drinking water that's not demonstrably safe". Stuff. Archived from the original on 4 October 2020. Retrieved 14 March 2020.
- ↑ "Government Inquiry into Havelock North Drinking-Water". dia.govt.nz. Department of Internal Affairs (New Zealand). Archived from the original on 2 April 2018. Retrieved 1 April 2018.
- ↑ Gilpin, Brent J.; Walker, Tiffany; Paine, Shevaun; Sherwood, Jill; Mackereth, Graham; Wood, Tim; Hambling, Tammy; Hewison, Chris; Brounts, Angela; Wilson, Maurice; Scholes, Paula; Robson, Beth; Lin, Susan; Cornelius, Angela; Rivas, Lucia; Hayman, David T. S.; French, Nigel P.; Zhang, Ji; Wilkinson, David A.; Midwinter, Anne C.; Biggs, Patrick J.; Jagroop, Anita; Eyre, Rachel; Baker, Michael G.; Jones, Nicholas (1 September 2020). "A large scale waterborne Campylobacteriosis outbreak, Havelock North, New Zealand". Journal of Infection. 81 (3): 390–395. doi:10.1016/j.jinf.2020.06.065. ISSN 0163-4453. Archived from the original on 4 April 2023. Retrieved 10 May 2023.
- ↑ Varrone, Liana; Glass, Kathryn; Stafford, Russell J.; Kirk, Martyn D.; Selvey, Linda (August 2020). "A meta-analysis of case-control studies examining sporadic campylobacteriosis in Australia and New Zealand from 1990 to 2016". Australian and New Zealand Journal of Public Health. 44 (4): 313–319. doi:10.1111/1753-6405.12998. ISSN 1753-6405. Archived from the original on 30 June 2023. Retrieved 11 May 2023.
- 1 2 "Multistate Outbreak of Multidrug-Resistant Campylobacter Infections Linked to Contact with Pet Store Puppies". US Centers for Disease Control. 3 October 2017. Archived from the original on 23 March 2021. Retrieved 26 October 2017.
 This article incorporates text from this source, which is in the public domain.
This article incorporates text from this source, which is in the public domain.
External links
- Campylobacter jejuni genomes and related information at PATRIC, a Bioinformatics Resource Center funded by NIAID Archived 26 August 2021 at the Wayback Machine
| Classification | |
|---|---|
| External resources |